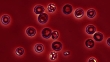

Plasmodium berghei, light microscopy - HD Stock-Video
Coloured light microscopy of red blood cells infected with Plasmodium berghei protozoa. P. berghei is the parasite that causes malaria in mice. The infected blood cells have a spiky shape. P. berghei is transmitted by the female Anopheles dureni mosquito. P. berghei cannot cause disease in humans but is used as a model organism for malaria research.

EINE LIZENZ KAUFEN
Individuelle Preisgestaltung: Sagen Sie uns einfach, wann, wo und wie Sie diese Datei nutzen möchten.
DETAILS
Bildnachweis:
Creative #:
521188696
Lizenztyp:
Rights-ready
Kollektion:
Image Bank Film
Max. Dateigröße:
1920 x 1080 px - 467 MB
Cliplänge:
00:00:14:04
Hochgeladen am:
Ort:
United Kingdom
Releaseangaben:
Keine Freigaben erforderlich
Gemastert mit:
QuickTime 8-bit Photo-JPEG HD 1920x1080 25p
- Blut,
- Ansteckende Krankheit,
- Rotes Blutkörperchen,
- Malaria,
- Parasit,
- Plasmodium,
- Krankheitserreger,
- Wissenschaft,
- 10 Sekunden oder länger,
- Biologie,
- Drehort außerhalb der USA,
- Echtzeit,
- Einzeller - Kleinstlebewesen,
- Extreme Nahaufnahme,
- Farbbearbeitung,
- Farbbild,
- Farbiger Hintergrund,
- Farbton,
- Film - Filmtechnik,
- Forschung,
- HD-Format,
- Horizontal,
- Kreis,
- Leuchtende Farbe,
- Lichtmikroskopische Aufnahme,
- Medizinische Forschung,
- Mikrobiologie,
- Modellorganismus,
- Murin,
- Niemand,
- Roter Hintergrund,
- Starke Vergrößerung,
- Vereinigtes Königreich,